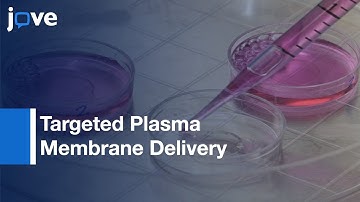
Hydrophobic Cargo Encapsulated In Liquid Crystal Nanoparticle Carrier l Protocol Preview

⬇ DOWNLOAD NOW
Kalau muncul iklan pop-up, tutup lalu klik tombol kembali
Download lagu Encapsulation Of Hydrophobic & Hydrophilic Compounds In Polymeric Nanoparticles l Protocol Preview secara gratis hanya untuk keperluan promosi. Dukung artis favorit kamu dengan membeli musik original di iTunes atau platform resmi lainnya.
 Microfluidic Strategies to Improve Encapsulation of Hydrophobic Drugs in Nanoparticles
Microfluidic Strategies to Improve Encapsulation of Hydrophobic Drugs in Nanoparticles
 Formulation: Diblock Polymeric Nanoparticles Through Nanoprecipitation Technique l Protocol Preview
Formulation: Diblock Polymeric Nanoparticles Through Nanoprecipitation Technique l Protocol Preview
 PLGA Nanoparticles Formed By Single Or Double-Emulsion With Vitamin E-TPGS l Protocol Preview
PLGA Nanoparticles Formed By Single Or Double-Emulsion With Vitamin E-TPGS l Protocol Preview
 PLA from PolySciTech used in research on improved encapsulation by use of counterions
PLA from PolySciTech used in research on improved encapsulation by use of counterions
 Production: Gliadin-Cyanoacrylate Nanoparticles For Hydrophilic Coating l Protocol Preview
Production: Gliadin-Cyanoacrylate Nanoparticles For Hydrophilic Coating l Protocol Preview
Hydrophobic Cargo Encapsulated In Liquid Crystal Nanoparticle Carrier l Protocol Preview
Hydrophobic Cargo Encapsulated In Liquid Crystal Nanoparticle Carrier l Protocol Preview
 Encapsulation
Encapsulation
 Continuous Formation of Polymeric Particles and Capsules Through Emulsification, Solvent Evaporation
Continuous Formation of Polymeric Particles and Capsules Through Emulsification, Solvent Evaporation